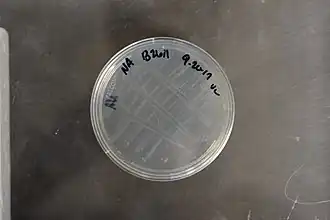

Comamonas
| Comamonas | ||||||||||||
|---|---|---|---|---|---|---|---|---|---|---|---|---|
Comamonas testosteroni | ||||||||||||
| Systematik | ||||||||||||
| ||||||||||||
| Wissenschaftlicher Name | ||||||||||||
| Comamonas | ||||||||||||
| (ex Davis and Park 1962) De Vos et al. 1985 |
Comamonas ist eine Gattung von Bakterien. Einige Vertreter sind für den Abbau von Schwermetallen und aromatischen Verbindungen interessant.[1]
Merkmale
Die Zellformen der Arten von Comamonas sind unterschiedlich, es können gerade oder leicht gekrümmte Stäbchen auftreten. Die Zellgröße liegt zwischen 0,3 und 0,8 μm in Breite und 1,1 – 4,4 μm in Länge. Teilweise treten auch längere Zellen auf, mit einer Länge von 5 – 7 μm. Auch Spirillen können auftreten. Die Zellen sind entweder einzeln oder bilden Paare. Die meisten Comamonas-Arten sind beweglich durch polare (an einen Zellende) oder bipolare Büschel von Flagellen (eine polytrich-monopolare oder polytrich-bipolare Begeißelung). Die Art C. guangdongensis ist peritrich begeißelt. C. koreensis besitzt keine Flagellen, es ist unbeweglich (nonmotil).[2][3]
Stoffwechsel und Wachstum
Gutes Wachstum erfolgt auf Medien mit organischen Säuren, Aminosäuren oder Peptide. Es werden nur wenige Kohlenhydrate genutzt. Die Arten unterscheiden sich u. a. vom Stoffwechsel her. So sind z. B. Comamonas terrigena und C. testosteroni auf Sauerstoff angewiesen (aerob) und chemoorganotroph. Der Stoffwechselweg ist hierbei die Atmung mit Sauerstoff als terminaler Elektronenakzeptor. Arten wie C. koreensis und C. nitrativorans können wiederum auch anaerob, also unter Ausschluss von Sauerstoff wachsen.[3]
Ökologie
Comamonas-Stämme sind häufige Bewohner von Boden, Schlamm und Wasser. Sie kommen auch häufig in verschmutzten Umgebungen vor, so beispielsweise in mit Schwermetallen kontaminierten Böden. Sie wurden auch aus verschiedenen klinischen Proben vom Menschen, aus der Krankenhausumgebung sowie aus Pferde- und Kaninchenblut isoliert worden. Stämme von Comamonas verursachen allerdings nur selten Infektionen beim Menschen.[4] Die Art Comamonas odontotermites wurde aus einem Darm einer Termite (Odontotermes formosanus) isoliert. Der Fundort von Comamonas zonglianii war innerhalb von mit Phenol belasteten Boden, Comamonas composti wurde aus einen Komposthaufen isoliert.[2]
Die Art Comamonas kerstersii ist ein Erreger von Peritonitis. Das Genom wurde 2018 vollständig sequenziert.[5]
Nutzung
Comamonas ist von starken Interesse für biochemische Anwendungen. Vertreter der Gattung sind, wie auch die näher verwandten Gattungen Burkholderia und Ralstonia, zum Abbau von vielen organischen und auch anorganischen Substraten in der Lage. So wurden Bakterienstämme von Comamonas von mit verschiedenen komplexen organischen Verbindungen und Schwermetallen stark kontaminierten Standorten isoliert. Zum Beispiel wurde ein gegen Cadmium resistenter Stamm in einen mit Schwermetallen belasteten Boden gefunden. Gegen Nickel resistente Stämme wurden aus natürlich nickelhaltigen Böden in Neukaledonien isoliert.[3] Es wurde des Weiteren beobachtet, das im Boden vorkommende Stämme von Comamonas mit steigender Konzentration von Vanadium zunehmen. Das Gleiche gilt zum Beispiel für die Bodenbakterien der Gattungen Acinetobacter und Sphingobacterium.[6] Comamonas ist auch in der Lage, die für Sonnenschutzmittel genutzte Verbindung Octisalate abzubauen. Andere Arten, die hierzu in der Lage sind, finden sich z. B. bei Mycobacterium, Pseudomonas, Rhodococcus und Acidovorax.[6]
Weitere aromatische Verbindungen, die mit Hilfe von Comamonas abgebaut werden könnten, sind z. B. Nitrobenzol.[7] So kann der Stamm Comamonas sp. JS765 die Verbindung als einzige Quelle für den Gewinn von Kohlenstoff, Stickstoff und Energie nutzen. Nitrobenzol ist giftig und gilt als möglicher Auslöser von Krebs.
Auch Polycyclische aromatische Kohlenwasserstoffe, wie z. B. Chinolin, Phenanthren und Naphthalin können abgebaut werden.[8][9]
Die Art Comamonas testosteroni kann das Steroidhormon Testosteron als einzige Kohlenstoffquelle nutzen. Testosteron und testosteron-ähnliche Substanzen zählen zu den sogenannten Umwelthormonen. Hierbei handelt es sich um künstlich hergestellte Hormone, die angehäuft in der Umwelt auftreten. Testosteron wurde in Gülle, Klärschlamm, Boden und auch im Trinkwasser gefunden.[10][11] Es sind für den Menschen gesundheitsschädliche Wirkungen von aufgenommenen Steroidhormonen bekannt. Sie können auf das Immun- und Herz-Kreislaufsystem und auf das Nervensystem wirken. Da Comamonas testosteroni in der Lage ist, Testosteron abzubauen, könnte es z. B. in Kläranlagen eingesetzt werden.[11] Des Weiteren ist diese Art in der Lage Poly3HB, ein Polyhydroxyalkanoat abzubauen, was für den Bereich Bio-basierten Kunststoffen von Interesse ist.[1] Auch den u. a. bei der Produktion von Medizinmitteln gebildetes 4-Chlorphenol kann Comamonas testosteroni abbauen. Chlorphenole sind giftig und können sich innerhalb von Böden anreichern. Sie entstehen u. a. bei der Herstellung von Medikamenten oder Pestiziden.[12][13][14] Ein von C. testosteroni isoliertes Enzym wird für die Herstellung der Ursodesoxycholsäure genutzt. Ursodesoxycholsäure wird z. B. als Mittel bei Erkrankungen der Leber medizinisch genutzt.[15] Das Genom von C. testosteroni wurde 2009 komplett sequenziert.
Systematik
Die Gattung Comamonas zählt zu der Familie der Comamonadaceae. Die Typusart ist Comamonas terrigena (ex Hugh 1962) De Vos et al. 1985. Comamonas wurde 1985 geschaffen und umfasste eine einzige Art, C. terrigena. Kurz nach der Beschreibung von Comamonas terrigena wurden Pseudomonas acidovorans und Pseudomonas testosteroni als Mitglieder der Gattung Comamonas zugeordnet. Comamonas acidovorans wurde jedoch wieder in Delftia acidovorans umklassifiziert. C. terrigena umfasste drei Stammcluster mit klinischen Isolaten vom Menschen, die jetzt als C. terrigena, C. aquatica und C. kerstersii geführt werden.[4] In der folgenden Zeit wurden weitere Arten beschrieben, im September 2023 wurden ca. 25 Arten geführt.[16]
Der Name wird gelegentlich falsch wiedergegeben als: „Comamon“, „Commamonas“, „Commonas“ oder „Comomonas“.
Es folgt eine Liste einiger Spezies:
- Comamonas aquatica (Hylemon et al. 1973) Wauters et al. 2003
- Comamonas aquatilis Kämpfer et al. 2018
- Comamonas badia Tago and Yokota 2005
- Comamonas composti Young et al. 2008
- Comamonas denitrificans Gumaelius et al. 2001
- Comamonas granuli Kim et al. 2011
- Comamonas guangdongensis Zhang et al. 2013
- Comamonas humi Hatayama 2014
- Comamonas jiangduensis Sun et al. 2013
- Comamonas kerstersii Wauters et al. 2003
- Comamonas testosteroni (Marcus and Talalay 1956) Tamaoka et al. 1987
- Comamonas zonglianii Yu et al. 2011
Einzelnachweise
- ↑ a b Alexander Steinbüchel: Mikrobiologisches Praktikum. Springer Verlag, Heidelberg 2003, ISBN 3-540-44383-5
- ↑ a b Eugene Rosenberg, Edward F. DeLong, Stephen Lory, Erko Stackebrandt und Fabiano Thompson: The Prokaryotes. Alphaproteobacteria and Betaproteobacteria ISBN 978-3-642-30197-1
- ↑ a b c George M. Garrity (Hrsg.): Bergey’s Manual of Systematic Bacteriology. 2. Auflage, Band 2: The Proteobacteria. Part C: The Alpha-, Beta-, Delta-, and Epsilonproteabacteria. Springer, New York 2005, ISBN 0-387-24145-0.
- ↑ a b John J. Lipuma, Bart J. Currie, Sharon J. Peacock und Peter A. R. Vandamme: Burkholderia, Stenotrophomonas, Ralstonia, Cupriavidus, Pandoraea, Brevundimonas, Comamonas, Delftia, and Acidovorax doi:10.1128/9781555817381.ch43 In: James H. Jorgensen, Karen C. Carroll, Guido Funke, Michael A. Pfaller, Marie Louise Landry, Sandra S. Richter, David W. Warnock: Manual of Clinical Microbiology, 2015, 11th Edition doi:10.1128/9781555817381
- ↑ Xiawei Jiang, Wenhong Liu & Beiwen Zheng: Complete genome sequencing of Comamonas kerstersii 8943, a causative agent for peritonitis In: Scientific Data Band 5, Article number: 180222 (2018) doi:10.1038/sdata.2018.222
- ↑ a b Parveen, M., Paul, S., Saha, K.K., Mandal, N.C. (2025). Exploring the Role of Earthworm Gut Bacteria in Minimizing the Noxious Effects of Xenobiotic Compounds on Plant Growth. In: Roy, S., Mandal, V. (eds): Plant-Microbe Interaction under Xenobiotic Exposure. Springer, Singapore. doi:10.1007/978-981-96-8260-7_22
- ↑ Johanes Ottow: Mikrobiologie von Böden: Biodiversität, Ökophysiologie und Metagenomik. Springer, 2011, ISBN 978-3-642-00824-5, S. 203.
- ↑ Xuwang Zhang, Lizhi Zhang, Minghuo Wu, Qidong Tang, Zhaojian Song, Hao Zhou, Yongming Bao, Lifen Liu und Yuanyuan Qu: Comparative characterization and functional genomic analysis of two Comamonas sp. strains for biodegradation of quinoline In: Chemical Technology and Biotechnology. Band 95, Ausgabe 7 doi:10.1002/jctb.6390
- ↑ A. K. Goyal, G. J. Zylstra: Genetics of naphthalene and phenanthrene degradation by Comamonas testosteroni In: Journal of Industrial Microbiology and Biotechnology, Volume 19, Issue 5-6, 1 November 1997, Pages 401–407, doi:10.1038/sj.jim.2900476
- ↑ Yi-Lung Chen, Chia-Hsiang Wang, Fu-Chun Yang, Wael Ismail, Po-Hsiang Wang, Chao-Jen Shih, Yu-Ching Wu und Yin-Ru Chiang: Identification of Comamonas testosteroni as an androgen degrader in sewage. In: Scientific Reports Band 6, Artikel Nummer: 35386 (2016).
- ↑ a b Tianyuan Pan, Pu Huang, Guangming Xionga und Edmund Masera: Isolation and identification of a repressor TetR for 3,17b-HSD 4 Q1 expressional regulation in Comamonas testosteroni In: Chemico-Biological Interactions Band 234, 5. Juni 2015, S. 205–212 doi:10.1016/j.cbi.2014.12.034
- ↑ Tobajas, M., Monsalvo, V. M., Mohedano, A. F., & Rodriguez, J. J.: Enhancement of cometabolic biodegradation of 4-chlorophenol induced with phenol and glucose as carbon sources by Comamonas testosteroni. (2012) In: Journal of Environmental Management, 95(Suppl), S. 116–121. doi:10.1016/j.jenvman.2010.09.030 Open Access
- ↑ Walter Reineke und Michael Schlömann: Umweltmikrobiologie. Springer Verlag, 2020. ISBN 978-3-662-59654-8 doi:10.1007/978-3-662-59655-5
- ↑ Shree Nath Singh: Microbe-Induced Degradation of Pesticides (= Environmental Science and Engineering). Springer International Publishing, Cham 2017, ISBN 978-3-319-45155-8, doi:10.1007/978-3-319-45156-5 (springer.com [abgerufen am 31. August 2023]).
- ↑ Horst Chmiel, Ralf Takors und Dirk Weuster-Botz: Bioprozesstechnik. Springer Spektrum, Berlin, Heidelberg, 2018, ISBN 978-3-662-54042-8 doi:10.1007/978-3-662-54042-8
- ↑ J. P. Euzéby: List of Prokaryotic names with Standing in Nomenclature (LPSN) Genus Celerinatantimonas (Stand: 20. September 2023).